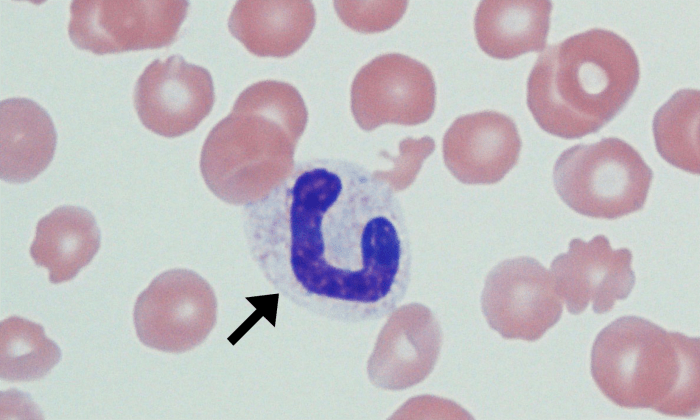
Bands 11 (Canine 4) ARROWS
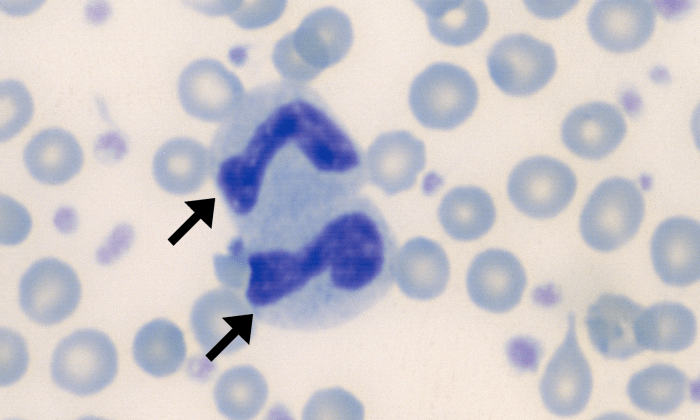
Bands 6 (Bovine 3) ARROWS

Bands (Left Shift)
Morphology: bands are immature neutrophils with an unsegmented horseshoe-shaped nucleus.
Commonly seen with: toxic change
Clinical relevance: left shift (↑ bands in peripheral blood) indicates inflammation. Left shift is more pronounced with more acute and more severe inflammation and is usually accompanied by toxic change. Inflammatory cytokines stimulate neutrophil production and release of both mature (segmented) and immature (band) neutrophils from the bone marrow.